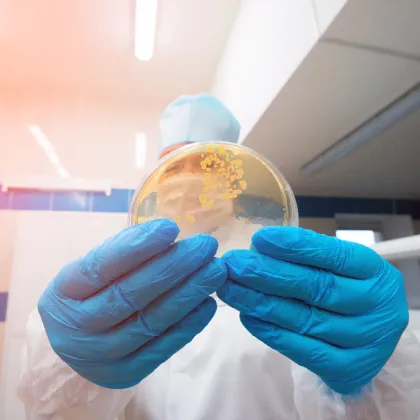
Enterococcus Faecium Probiotic Wholesale

Chobani Probiotic Milk Drinks
Brand Introduction
The Advantages Of Chobani Probiotic Milk Drinks:
Chobani Probiotic is a line of yogurt-based drinks that combine probiotics with delicious flavors for gut health.
$4.0000
- $
5.0000
box
$30
- $
50
tin box
Min.order : 10 tin box
$0.0600
- $
0.0700
Piece/Pieces
$0.3900
- $
0.6500
piece
Min.order : 1 piece
$345
- $
425
Kilogram
Min.order : 1 Kilogram
$0.8600
- $
0.9000
piece
Min.order : 1 piece
$13.6800
- $
15.3400
piece
Min.order : 1 piece
$150.0000
- $
240.0000
piece
Min.order : 1 piece
$1
- $
55000
Set/Sets
Min.order : 1 Set/Sets
$12.1200
- $
12.8700
carton
Min.order : 1 carton
$50.0000
- $
80.0000
Kilogram
Related Brand:
Taifu
, UZHEN
, Bugs Bunny
, Brand Good +1
, Vitasoy
, Werdery
, WEICHUAN
, Youyic
, Mengniu Sour Milk Drink
, Yakult
Related Industry:
Goat milk
, Camel milk powder
, yogurt
, High calcium milk
, milk
, Pure milk
, Buffalo Milk
, Cheese
, Double skin milk
, Skimmed milk
, condensed milk
, Skimmed milk powder
, Whole milk
, Fresh milk
, Student milk
, Milk powder for middle-aged and elderly people
, Empty milk
, Women's milk powder
, Milk beer
, Lactobacillus beverages
, coffee
, Coffee drinks
, Coffee beans
, Black coffee
, Capsule coffee
, Ear-hanging coffee
, Cocoa powder
, Soy milk powder
, Soy milk
, Beanflower
, Oat milk
, oatmeal
, Pueraria root powder
, lotus root starch
, Almond powder
, Walnut powder
, Sesame paste
, Coconut powder
, Cereal breakfast
, Plant protein drinks
, Corn juice
, Wheat germ
, Sour plum powder
, Ice cream powder
, Ice powder
, Coconut juice
, Coconut water
, Coconut milk
, Coconut milk
, Grape juice
, Apple juice
, juice
, Green juice
, Apple cider vinegar
, Sugar-free drinks
, Cola
, Sports drinks
, drinks
, Functional beverages
, Carbonated beverages
, Electrolyte beverages
, Solid drinks
, Bubble water
, Soda water
, salt soda water
, Bottle water
, Pure water
, drinking water
, Chia Seeds
, Vegetable Cream
Recommended Related Videos

Please Send Message
${inquiryTitle}